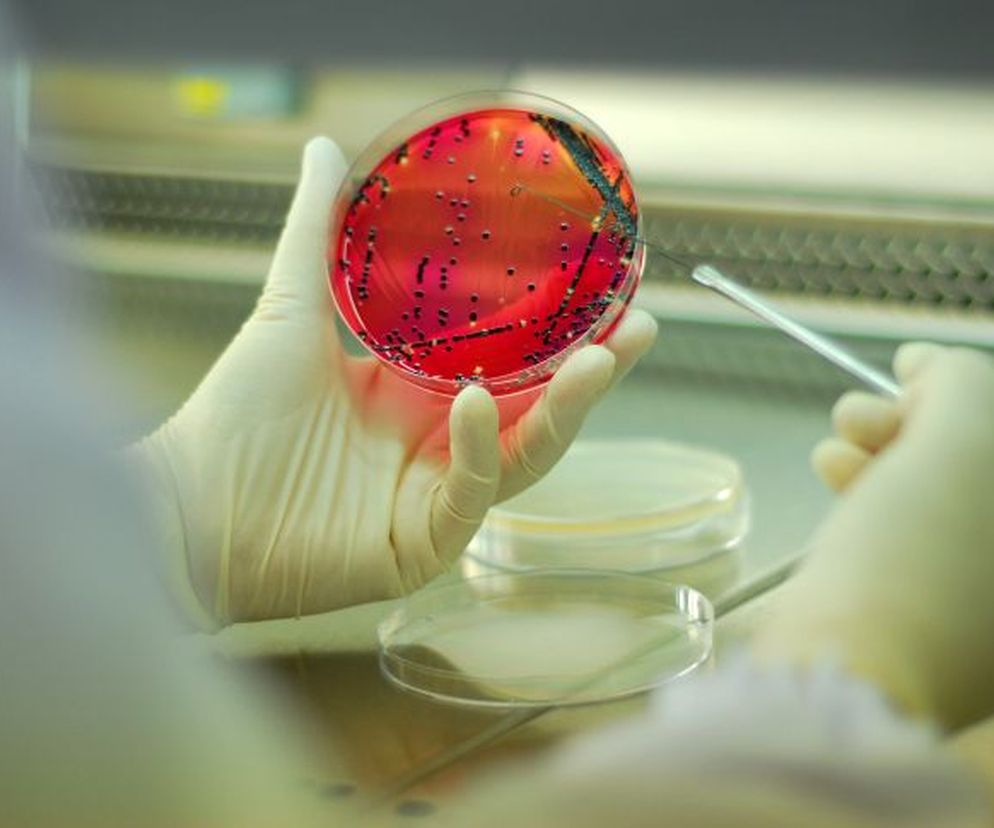
Zakażenie szpitalne: przyczyny zakażeń szpitalnych

Spis treści
Zakażenie szpitalne to infekcja, do której doszło w szpitalu, albo ujawniła się podczas hospitalizacji (minimum 48 godzin po przyjęciu) lub po wypisaniu pacjenta, a jej przyczyną jest udokumentowany epidemiologicznie czynnik chorobotwórczy pochodzący od innego chorego lub pracowników szpitala albo przez endogenny czynnik mikrobiologiczny - pisze Elżbieta Narolska-Wierczewska w swojej pracy i dodaje: zakażenia szpitalne mogą występować stale z częstotliwością charakterystyczną dla oddziału (endemia) lub pojawić się gwałtownie jako ognisko zachorowań (epidemia).
Okazuje się też, że typowe zakażenia szpitalne - egzogenne, czyli krzyżowe, mają swoje źródło w przeniesieniu na pacjenta czynnika zakaźnego z innego chorego, osoby z personelu czy ze środowiska szpitalnego. Zakażenia szpitalne endogenne są spowodowane własną mikroflorą chorego (patologiczną lub oportunistyczną).
Zakażenia szpitalne: przyczyny środowiskowe
Według Elżbiety Narolskiej-Wierczewskiej potencjalne przyczyny środowiskowych zakażeń szpitalnych to:
- brudne ręce personelu
- zanieczyszczona odzież personelu
- niejałowy sprzęt medyczny
- nieodkażony sprzęt niemedyczny oraz skażone otoczenie pacjenta
- niewłaściwe sprzątanie
W Unii Europejskiej corocznie zdarza się 2,5 mln zakażeń szpitalnych, które są przyczyną nawet 90 tys. zgonów - wynika z raportu opublikowanego przez "Plos Medicine".
- niewłaściwy podział pracy: angażowanie osób nieprzygotowanych, zwłaszcza w sytuacjach szczególnych, „wypożyczanie” personelu z innych oddziałów, brak procedur i standardów
- złe warunki pracy: zbyt duże obciążenie personelu, nadmierne obłożenie, wprowadzanie nowych wymagań bez szkolenia i treningu
- przyjmowanie chorych, wymagających szczególnych warunków hospitalizacji bez możliwości zapewnienia tychże warunków
- złe warunki sanitarno-higieniczne placówek, brak procedur i standardów
- brak systemu kontroli zakażeń w placówce: brak procedur i standardów, brak fachowców
Zakażenia szpitalne: źródła
- nosiciele (zdrowi i ozdrowieńcy)
- personel szpitalny
- sprzęt szpitalny nieodpowiednio sterylizowany i dezynfekowany (aparatura diagnostyczna, narzędzia chirurgiczne i zabiegowe, materiały opatrunkowe)
Najczęstszymi w Unii infekcjami szpitalnymi są zakażenia dróg moczowych, ran pooperacyjnych oraz zapalenia płuc. Na każde nich przypada 20 proc. wszystkich tego rodzaju infekcji.
- przedmioty osobiste - bielizna, odzież, pościel, buty szpitalne, materace, koce, poduszki
- przedmioty szpitalne - łóżka, meble, klamki, sedesy, nocniki, kaczki, baseny, wanny, butelki, mydelniczki
- leki - krew, plazma, krople do oczu, środki dezynfekcyjne stosowane do odkażania ran
- żywność i woda
Czynniki zwiększające ryzyko zakażenia szpitalnego
- immunosupresja
- niedobory odporności
- choroby współistniejące, np. cukrzyca
- wiek: dzieci do 1. roku życia, szczególnie: wcześniactwo, osoby starsze
- długotrwałe stosowanie antybiotyków
- inwazyjne procedury diagnostyczne, lecznicze i pielęgnacyjne-cewniki naczyniowe obwodowe i centralne, cewnik moczowy, żywienie parenteralne, endoskopie
Zdecydowana większość zakażeń szpitalnych związana jest z inwazyjnymi procedurami, takimi jak używanie cewników wprowadzanych do naczyń krwionośnych i dróg moczowych oraz mechanicznej wentylacji płuc.
- przerwanie ciągłości tkanek: zabiegi operacyjne, oparzenia
- długotrwałe lub wielokrotne hospitalizacje: kolonizacja przewodu pokarmowego i układu oddechowego szczepami szpitalnymi
- pobyt w domu dziecka
- ograniczenie diagnostyki mikrobiologicznej
- ograniczenie ilości zlecanych badań
- nadużywanie w terapii empirycznej antybiotyków o szerokim spektrum - cefalosporyny III gen.
- stosowanie leków bez wskazań-zakażenia wirusowe
- zbyt krótki czas terapii
- ograniczenie stosowania terapii celowanej
CZYTAJ TEŻ:
- Zakażenie szpitalne: superbakterie odporne na antybiotyki. Zakażenia w szpitalu leczenie i objawy
- Jak uzyskać odszkodowanie za zakażenie szpitalne przed komisją?
- Zakażenia szpitalne - odpowiedzialność materialna szpitala i lekarza w wypadku zakażeń
Przy pisaniu tego tekstu korzystałam z pracy "Zakażenia szpitalne - problem medyczny, prawny, ekonomiczny i etyczny" Elżbiety Narolskiej-Wierczewskiej z Oddziału Nadzoru Przeciwepidemicznego WSSE w Bydgoszczy